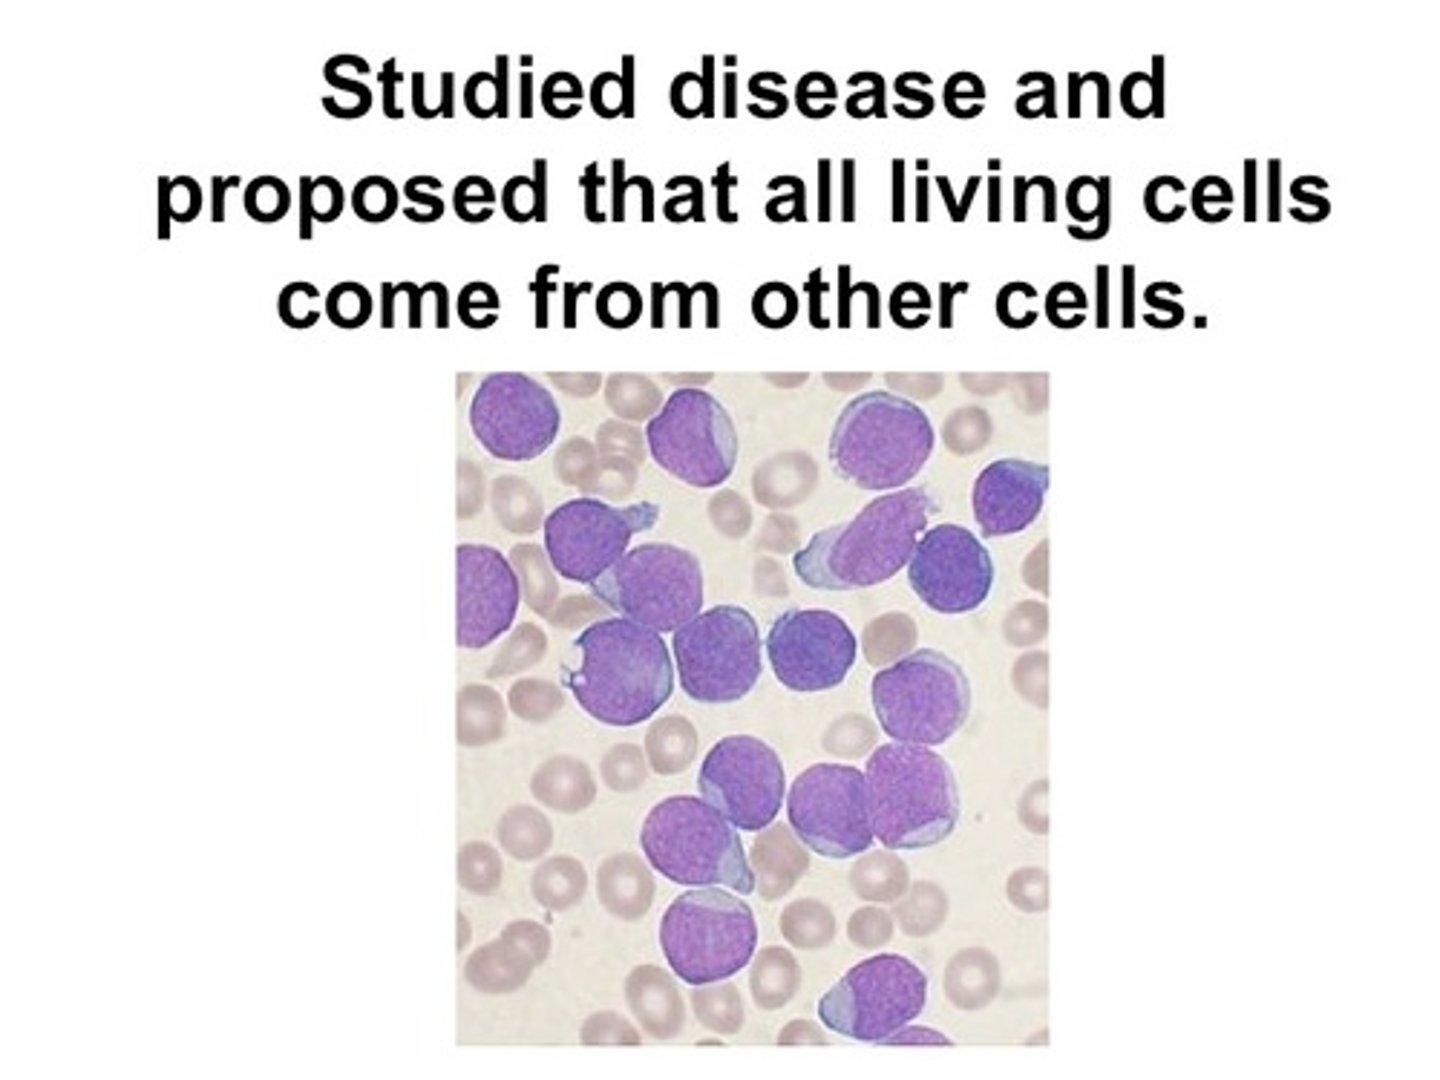

1/22
Looks like no tags are added yet.
Name | Mastery | Learn | Test | Matching | Spaced |
|---|
No study sessions yet.
Cells

Anton van Leeuwenhoek

Robert Hooke

Matthias Schleiden

Theodore Schwann

The Cell Theory is . . .

Rudolph Virchow
Part I of the cell theory states that . . .

Part II of the cell theory states that . . .

Part III of the cell theory states that . . .

Nucleus
a part of the cell containing DNA and RNA and responsible for growth and reproduction, SOME Genes are founds in the Mitochondria and Chloroplasts
Prokaryote
single celled
no nucleus
no membrane inside cell
Eukaryote
Cells that contain an nucleus and membrane-bound organelles such as endoplasmic reticulum, chloroplasts, mitochondria and Golgi apparatus
Organelle
is a small body in a cell's cytoplasm that is specialized to perform a certain function -- Cell Organs
Chloroplast
GREEN BLOBS....organelle bounded by a double membrane containing the enzymes and pigments that perform photosynthesis; occur only in eukaryotes.

Mitochondria
Organelle responsible for producing energy in animals, plants, and fungi --- breaks down food to make ATP "ENERGY" (CELL RESPIRATION)
"Powerhouse" of the cell

cell wall
Structure found in prokaryotic cells and eukaryotic plant cells that provides support and protection for the cell

Cell membrane (plasma membrane)
Outside layer of most eukaryotic cells --- "Bouncer," controlling what enters and leaves the cell

Diaphragm
LEVER OR KNOB -- regulates the amount of light that enters the body tube of a microscope?

microscope objective lens
low, medium, and high power

ocular lens
Eye Piece Lens

fine adjustment knob
this knob sharpens an image under low and medium power

transparent
easily seen through, as in glass
